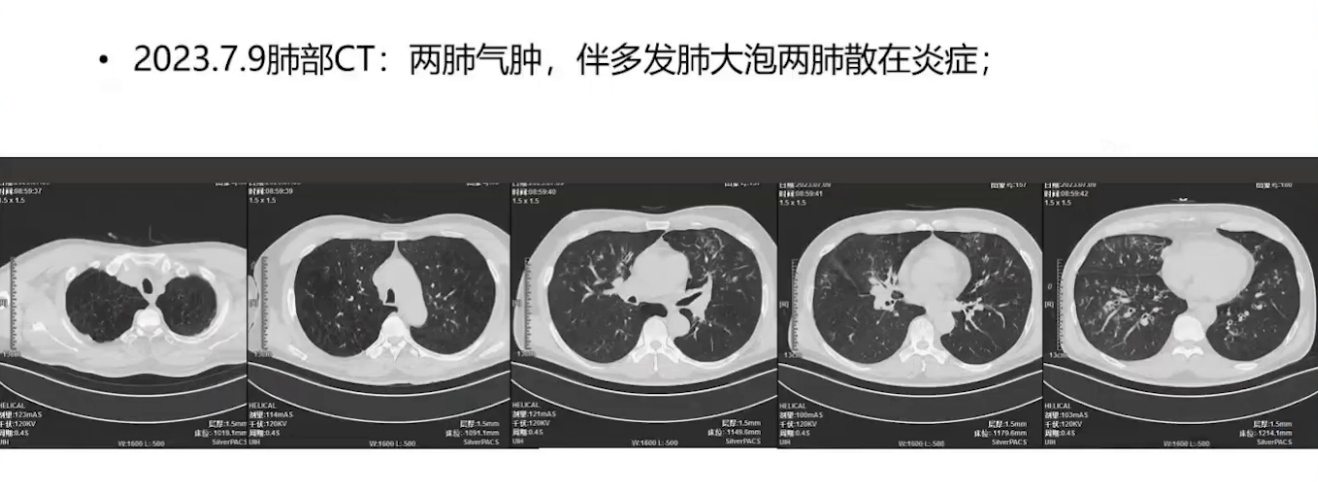
图片 1.png

查看更多
密码过期或已经不安全,请修改密码
修改密码
壹生身份认证协议书
同意
拒绝
同意
拒绝
同意
不同意并跳过
59岁中年男性,主诉反复咳嗽、气急5年,再发加重5天。
5年前受凉后出现反复咳嗽、咳痰伴气促,治疗后易复发。4年前于我院门诊确诊为慢阻肺,初始使用单支扩剂噻托溴铵粉吸入治疗。2年前门诊复查肺功能提示重度阻塞性通气功能障碍,支气管舒张试验阳性,遂改为双支扩剂乌美溴铵维兰特罗吸入剂治疗,配合复方甲氧那明联合孟鲁司特钠不规则口服,症状控制尚可。5天前,患者因情绪激动及受凉后出现发热,最高体温达39.5℃,伴咳嗽咳痰,痰呈黄绿色,气急加重,夜间端坐呼吸,双下肢水肿。我院急诊查血常规,白细胞17.7×10⁹/L,中性粒细胞比例86.3%,C反应蛋白183.73 mg/L。急诊予甲泼尼龙、左氧氟沙星静滴3天后,体温恢复正常,但咳嗽咳痰气促仍存,为求进一步治疗,以慢阻肺伴急性加重收住入院。
既往史
慢性胃炎、消化性溃疡病史。
个人史
吸烟40余年,每天1包,近1年7-8支。
辅助检查
(1)体格检查
基本生命体征尚稳定,R 22次/分,BP 149/81mmHg,T 36.9℃,2L/min吸氧下SpO2 91%。口唇无发绀,肺部呈桶状胸改变,肋间隙增宽,呼吸音减弱,双肺散在干湿啰音,心律齐,双下肢无明显水肿。
(2)实验室检查
血常规白细胞较前增高至18.97×10⁹/L,中性粒细胞84%,CRP下降至67.26mg/L;血气分析未见明显Ⅱ型呼衰改变;其他常规血液化验未见明显异常;风湿两项中类风湿因子(RF)值轻度增高至22KU/L,但患者既往无关节疼痛及关节畸形,考虑为感染急性期引起的RF值轻度异常。过敏原全套阴性,IgE 29IU/L。
(3)影像学检查
心电图:窦性心律,前间壁T波低平,电轴右偏,顺钟向转位。
心脏超声:升主动脉增宽,主动脉瓣轻度反流,二尖瓣轻度反流。
腹部B超:肝内钙化灶,胆囊息肉样病变。
入院时肺部CT:两肺气肿伴多发肺大泡,双肺散在炎症性改变。肺气肿呈双肺对称小叶中央型分布,炎症主要位于左肺舌段、右肺中叶及双下肺基底段,呈支气管播散样渗出影。
入院诊断
1、慢性阻塞性肺疾病伴急性加重;2、社区获得性肺炎;3、慢性胃炎;4、消化性溃疡。
诊治经过
予哌拉西林他唑巴坦针4.5g ivgtt q8h联合阿奇霉素片0.5 po qd抗感染;甲泼尼龙抗炎;氨溴索化痰,三联雾化等治疗。
进一步检查:

咳嗽、气急明显缓解,2023.7.15加用布地格福气雾剂吸入。
2023.7.18出院,CAT评分20分,mMRC2级;随访家中可耐受平地行走、驾车出行、花园做简单园艺。
病情进展再次入院
患者受凉后出现咳嗽咳痰伴气急加重,夜间端坐呼吸,有双下肢水肿。来我院急诊查血常规:N% 0.820,CRP 20.44mg/L;抗呼吸道合胞病毒抗体IgM弱阳性。后至当地卫生院,予左氧氟沙星静滴2天后患者热退,但咳嗽、咳痰、气促仍有,伴双下肢水肿。为求进一步治疗以“慢性阻塞性肺疾病伴有急性加重”收入我院。
肺部CT显示肺气肿,既往肺部感染灶基本吸收,无新发渗出影。
予莫西沙星针0.4g ivgtt qd抗感染,甲泼尼龙抗炎,氨溴索化痰,三联雾化等治疗。气急缓解不理想,CAT评分35分,mMRC4级。
气急缓解不理想,CAT评分35分,mMRC 4级。治疗方案调整:间断无创通气,加氧疗;激素缓慢减量;吸入药物调整,停布地格福,改倍氯福格吸入(2吸 bid)。
2023.12.25患者出院,家中持续吸氧,间断无创通气(10h/天)。家中活动能力差,夜间不敢平卧,趴坐休息为主,下肢浮肿;轻度活动心率至120-140bpm,无创通气后心率可缓慢下降至100bpm左右;焦虑,抑郁情绪明显;CAT评分30分;2024.3.5咨询临床试验。
2024.3.6开始使用度普利尤单抗针300mg皮下注射q2w,首剂加倍。2024.3.17开始自觉呼吸费力情况较前改善,吸入药物使用更顺畅;2024.5.1自诉可耐受太极拳、八段锦、打桩,CAT评分21分;2024.10.30于上海胸科医院就诊,给予伊曲康唑胶囊0.2g po bid,1周后自觉活动后气急有进一步改善。


目前随访
已脱离无创通气,偶尔吸氧;能耐受长距离外出活动,上下2层楼,八段锦、太极拳;活动后心率100次/分以内,静息心率70-80次/分左右;情绪乐观积极。
查看更多
专家点评
选择此病例的原因,它特别之处在于:COPD患者通过FeNO增高确认有气道2型炎症,在常规治疗基础上加用生物靶向治疗,获得了良好的疗效。
我国COPD疾病负担重,基层医疗机构收治的患者往往CAT评分高、反复急性加重、住院率高,是当前特别是秋冬季诊疗的重点与难点。
对于这类反复急性加重的重症患者,在吸入三联疗法基础上,若病情仍控制不佳,后续选择有限,往往只能依赖口服激素、家庭氧疗或无创通气等支持手段,患者生活质量通常较差。
近年来,随着对慢阻肺异质性的深入认识,约三分之一的患者存在以2型炎症为特征的病理生理过程。对于这类患者,若经评估具备2型炎症生物标志物,如外周血嗜酸性粒细胞增高或FeNO升高,在充分排除急性细菌感染、真菌感染等禁忌后,可考虑在标准治疗基础上联用生物靶向制剂,如抗IL-4Rα单抗度普利尤单抗。这为传统治疗反应不佳的特定表型患者提供了新的重要治疗选择。